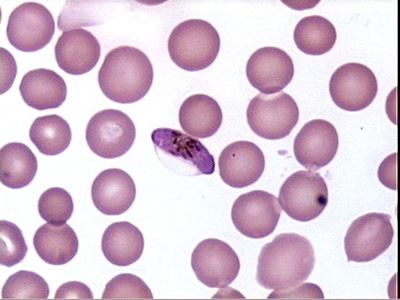
plasmodium-falciparum
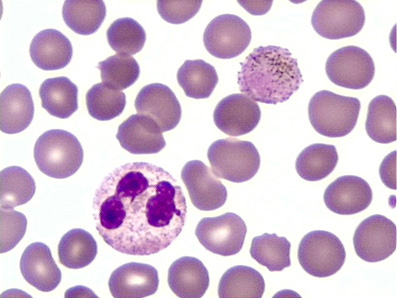
трехдневная-малярия

Малярия. Мой опыт болезни. Советы
Малярия - это то заболевание, которое в наших широтах обычно путают с гриппом и прочими ОРВИ. Особенно широко это распространено в зимний период: в это время года люди чаще ездят отдыхать в тропические страны, в которых малярия чувствует себя, как дома, потому что тропики - это и есть ареал обитания возбудителей малярии.
Симптомы малярии очень схожи с симптомами гриппа, и я сам, когда был инфицирован малярийным плазмодием, списывал всё на грипп. Однако, это могло стоить мне жизни, как многим другим людям, которым не смогли вовремя поставить верный диагноз. Но меня пронесло, и сейчас я хотел бы поделиться с вами своим опытом борьбы с малярией.
Что такое малярия?
Если говорить медицинским языком, то малярия - это Плазмодиоз, т.е. заболевание, вызываемое паразитическими одноклеточными протистами рода Plasmodium. Малярией мы заболеваем после укуса комаров рода Anopheles. Когда комариха (кусают только самки) впрыскивает свою слюну в ранку, то вместе со слюной (комар вводит вещества, препятствующие свёртыванию крови) в нашу кровь попадает и малярийный плазмодий. Малярийные комары обитают почти по всему Земному шару, в том числе и на территории России. Другое дело, что малярийных плазмодиев у нас нет, ибо они не приживаются к таким низким температурам.

Отличие малярийного комара Anopheles от других видов
Заразиться малярией в наших широтах, как и в любых других, можно в том случае, если инфицированного плазмодиями человека укусил комар рода Anopheles (только этот). Комар выпил какое-то количество инфицированной крови, после чего, согнанный, перелетел на другого бедолагу, которому уже передал озверевших плазмодиев вместе со своей слюной. Либо при инъекции двум людям одним и тем же шприцем (как при ВИЧе, гепатите). Других способов передачи малярии не существует. Также, если вы подхватили плазмодия в тропиках, значит его вам передал комар от какого-то больного малярией человека. Воздушно-капельно и как-либо иначе малярия не передаётся!

Существует 5 видов малярии, каждый из которых отличается степенью опасности:
- Plasmodium falciparum - наиболее распространённый паразит, вызываемый около 80-85% случаев заболеваемости. Этот вид плазмодия вызывает самую тяжёлую форму заболевания - тропическую малярию. Заболевание развивается стремительно, часты случаи летального исхода при неправильной диагностике и несвоевременном лечении. Часто протекает с осложнениями. Высокая смертность, практически все смертельные случаи малярии происходят при заражении этим плазмодием. Температура чаще постоянна, редко скачет. Большой набор симптомов характеризуется тем, что P. falciparum развивается в капиллярах внутренних органов, задерживая их кровоснабжение, что приводит к их патологии и проявлению симптомов, связанных с ними. Рецидив возможен после 1-2 лет от излечения;
- Plasmodium vivax - возбудитель трёхдневной малярии. Около 20% мировых случаев. Болезнь названа так, потому что лихорадка, как правило, возникает через каждые 48 часов (например, 1 числа была лихорадка, 2 - выходной, 3 - снова симптомы). Это обуславливается сроками размножения плазмодия vivax внутри эритроцитов. В начале заболевания температура держится постоянно, также приступы бывают и через день, и по два на дню. Длительность приступа - около 1-2 часов. Средне-тяжелый вид плазмодиоза. Рецидив возможен после 3-5 лет;
- Plasmodium ovale - аналогичен плазмодию vivax, вызывает трёхдневную малярию. Редкий вид;
- Plasmodium malariae - возбудитель четырёхдневной малярии. Приступы происходят каждые 72 часа (1 - лихорадка, 2, 3 - выходной, 4 - опять лихорадка), на четвёртый день. Длительность приступа - 8-10 часов. Самый слабый и редкий вид малярии. Рецидив возможен после 10 и более лет;
- Plasmodium knowlesi - новый вид малярии. Преимущественно заражает только макак, обитающих в Юго-Восточной Азии, но им также может быть инфицирован человек. В некоторых районах ЮВА около 70% случаев заражения. Безрецидивная форма малярии. Смертность низкая (2%) [1], [2].
Иммунитет к малярии возникает только частичный, после большого количества случаев инфицирования, в течение нескольких лет. Он возникает только к конкретному виду (штамму) малярии и усиливается с каждым новым разом. Симптомы со временем становятся слабее, а возможность летального исхода практически сводится к минимуму. Вакцины от малярии не существует! Ведутся разработки и клинические испытания вакцины против тропической формы, но и она не убережёт вас от всех видов плазмодиоза сразу. При этом она показала слабую эффективность (около 35%).
Симптомы малярии
Когда я путешествовал в Папуа - Новой Гвинее, я, разумеется, прекрасно знал о том, что этот регион очень богат не только на природные ресурсы, но еще и на малярийного плазмодия. И перед тем, как поехать в такую глушь, я затарился хорошим антималярийным препаратом. Т.е. я был готов к этому заболеванию, я знал его симптомы и знал, как его лечить. Но теория - теорией, а на практике зачастую всё оказывается совсем иначе, ведь невозможно всё предусмотреть.

Когда я впервые почувствовал симптомы лихорадки и озноба, то первым делом сразу же подумал именно на малярию и ни на что иное. Местные жители в этом эндемичном регионе болеют очень часто и малярия в Новой Гвинее - это самое популярное заболевание. Я отправился в местную больницу, чтобы сделать экспресс-тест на малярию. Тест показал отрицательный результат. Я спросил врача, тогда как мне быть с моими симптомами, на что врач ответил, что мне необходимо принимать Панадол (Парацетамол) по две таблетки каждые 6 часов. Т.е. обычная, классическая терапия при ОРВИ - просто снимать неприятные симптомы (температуру) парацетамолом и ждать, пока иммунная система сама вылечит вас от вирусов. Кроме того, я еще употреблял антибиотик амоксициллин, полагая, что симптомы простуды могут быть вызваны бактериями, т.е. пил на всякий случай, не имея представления о реалиях.
Возможные симптомы малярии
- Лихорадка - временное повышение температуры тела из-за интоксикации организма продуктами жизнедеятельности плазмодия. Лихорадка имеет циклический вид. Как правило, температура поднимается резко, достигает своей пиковой величины (38-40°) и падает, вплоть до нормальной температуры тела (36,6-37°). Циклы могут быть 4-х дневными, 3-х дневными и постоянными. Температура может изменяться в течение одного дня несколько раз, даже при трёхдневной малярии (все виды);
- Озноб - ощущение холода при повышении температуры на первой стадии лихорадки (все виды);
- Жар - ощущение жара при понижении температуры, покраснение кожи, после озноба, вторая стадия лихорадки (все виды);
- Потовыделение - при теплоотдаче, третья стадия лихорадки (все виды);
- Покалывание в коже - неприятные ощущение, похожие на слабые комаринные укусы (все виды);
- Судороги, мышечная дрожь - если температура повышается до 39-40° и выше. Тело начинает трясти, мышцы сокращаться. Возникает это от того, что тело, ощущающее холод, начинает сокращать мышцы (как при реальном холоде, морозе), чтобы тем самым выделить необходимое тепло для обогрева внутренних органов (все виды);
- Сухой кашель - частое явление;
- Боль в суставах - не у всех видов малярии (P. falciparum);
- Тошнота, рвота - иногда, на фоне повышенной температуры как побочный эффект;
- Диарея - иногда с кровью (P. falciparum);
- Головная боль - проявляется не всегда (в основном P. falciparum);
- Анемия - снижение гемоглобина в крови, бледность кожных покровов, проявляется не сразу (все виды);
- Низкий сахар в крови - проявляется не сразу;
- Гемоглобин в моче - проявляется не сразу;
- Гепатоспленомегалия - увеличение селезенки и печени при запущенной форме (все виды);
- Гепатит нефрозо-нефрит - почечно-печеночная недостаточность, желтуха (P. falciparum);
- Геморрагический синдром - кровотечение слизистых оболочек, приводит к смерти (P. falciparum);
- Кома - при запущенной форме, приводит к смерти (P. falciparum);
- Параличи - редко, при запущенной форме (P. falciparum).
- Отёк мозга - проявляется редко, при молниеносном течении заболевания на ранних стадиях может привести к смерти (P. vivax);
Не все симптомы проявляются сразу и не у всех форм малярии. Основные симптомы - лихорадка, головная боль, анемия, увеличение печени и селезенки. Смерть чаще всего происходит от перегрева при повышении температуры выше 42°, а также от энцефалопатии - комы или отёка мозга. Малярия при беременности может вызвать гибель плода, при P. falciparum и P. vivax. Наиболее восприимчивы к заболеванию дети постгрудного возраста (от 1 года, до 5 лет), беременные женщины и ранее не болевшие взрослые (например, туристы).
Таким образом, я просто жил, принимая парацетамол во время возникновения симптомов. А симптомы продолжались постоянно. Температура то падала, то опять поднималась - циклически. Потом как-то раз в Бангкоке я вместо 2 таблеток парацетамола принял 1 - и тут меня как затрясло! Градусника у меня не было, но я уверен, что было за 40 градусов, и сильная лихорадка, с судорогами, как после холодной воды.
Затем я приехал домой и дома еще одну неделю жил с этими симптомами, которые то появлялись, то пропадали. Я пил парацетамол, снимая их. Хотелось бы сказать, что суточной дозой парацетамола является 1 г, я же употреблял 3 г в день, т.е. по 6 таблеток (по 2 за раз). Иногда 4. Почему я сразу по приезду домой не обратился к врачу? Потому что я считал, что после постоянного приёма антибиотиков мой иммунитет слегка ослаблен, и поэтому организм борется с вирусом гриппа медленнее.
P. falciparum под микроскопом (Гаметоцит)
Эритроцит, зараженный P. vivax
Хочется отметить, что при подобных ситуациях многие люди списывают эти симптомы на ОРВИ и исключают возможность наличия малярии. Даже когда они идут ко врачу, то зачастую врачи тоже ставят диагноз ОРВИ, ехидно при этом насмехаясь над невежественными пациентами. Даже когда те намекают им: а не малярия ли у меня?! Однако, кто тут невежественный, это еще нужно установить! Нередки случаи летального исхода таких пациентов после неправильной постановки диагноза горе-терапевтами! Люди лечат простуду и умирают в итоге от малярии, когда их организм становится уже не в силах сопротивляться огромному количеству малярийных плазмодиев, которые за это время сильно размножились в их организме.
Примерно 100 лет назад малярией лечили сифилис. Больных сифилисом специально заражали малярией, чтобы вызвать повышение температуры тела до 41-42°, при которой возбудитель сифилиса погибает. Малярию же после этого лечили традиционно - хинином.
И вот как-то раз, когда я снова почувствовал сильную лихорадку с тряской (мышечной дрожью), при которой я даже не мог встать с постели, то я понял, что дела плохи, и это, скорее всего, не простуда. Как только мне стало лучше, я измерил температуру: она была 40,2°. Это при том, что она как раз уже шла на спад, в соответствии со своим циклом. Значит, во время дрожи она была, очевидно, выше. Я решил вызвать скорую, чтобы она отвезла меня в инфекционное отделение нашей городской больницы (я бывал уже там), а там мне могли бы точно поставить диагноз, без моих невежественных дилетантских гадалок, и я бы мог получить соответствующую терапию.

Лопнувшие эритроциты выпускают новое поколение плазмодиев
Я поступил в больницу с предварительным диагнозом, который поставили работники скорой помощи - "Лихорадка неизвестного генеза". Это наиболее адекватный диагноз при подобных симптомах в подобной ситуации (пациент прибыл из эндемичного региона), ни о каком ОРВИ или брюшном тифе (часто путают с малярией) речи не шло. В больнице взяли все необходимые анализы, исключили наличие пневмонии, туберкулёза, ну, и, разумеется, простуды. До готовности первых результатов анализа крови были две версии моего диагноза: сепсис (заражение крови) и малярия. После готовности анализа на стерильность (по сепсису) и "Толстой капли" диагноз установили точный - малярия. Значит, я ошибся, значит, ошибся экспресс-тест, и у меня всё-таки малярия. Однако, некоторые тест-полоски способны выявлять только антигены (протеины) возбудителя тропической малярии и не видеть три других вида. Так что, возможно, мне попался именно такой тест, на тропическую форму.

Тест-полоска: 1- отсутствие плазмодия; 2 - P. falciparum; 3 - комбинированный; 4,5 - испорченный тест.
Лечение малярии
В моей крови был обнаружен Plasmodium vivax - возбудитель трёхдневной малярии. Адекватной терапией является приём препаратов, наподобие Хинина. Хинин - это препарат, который получают из коры хинного дерева. Этим веществом лечили малярию люди с незапамятных времён. В России используется Хлорохин, который выпускается под различными названиями, наиболее популярным является - Делагил. Также я поставил в известность врачей о том, что у меня имеется Хинин, купленный за рубежом. Я пил и его, выпив 4 таблетки еще до приёма делагила. После чего почувствовал явное улучшение самочувствия, спад температуры - она больше не поднималась.
Лечение малярии в России: Хлорохин (Делагил / Иммард / Плаквенил)
- 4-х дневная (P. malariae) - 1-й день: 1.5 гр, 2-й день: 0.5 гр, 3-й день: 0.5 гр;
- 3-х дневная (P. vivax, P. ovale) - 1-й день: 1.5 гр, 2-й день: 0.5, 3-й день: 0.5, 4-й день и далее (в течении 2 недель) + Примахин (для профилактики рецидивов);
- Тропическая (P. falciparum) - 1-й день: 1.5 гр, 2-й день: 0.5 гр, 3-й день: 0.5 гр, 4-й день: 0.5 гр, 5-й день: 0.5 гр, далее + Примахин. - [3]
Для лечения тропической малярии данная терапия устарела из-за появления резистентности некоторых штаммов P. falciparum к хлорохину!
Другие препараты (доза для взрослого)
- Фансидар (Сульфадоксин+Пирематамин) - однократно, 3 таблетки;
- Примахин - 3 таб/день, в течении 2-х недель;
- Хинин - 500-700 мг, через каждые 7-8 часов, в течении 7-10 дней;
- Лариам (Мефлохин) - 1 гр однократно;
- Коартем (Артеметер+Люмефантрин) - 4 таб, утром и вечером, в течении 3-х дней;
- Маларон (Атоваквон+Прогуанил) - 4 таб в день, в течение 3-х дней.
- Бигумаль (Прогуанил) - 1.5 гр в течении 4-5 дней
- Хиноцид - 300 мг, 1-2 раза в день
Для лечения Тропической малярии (p. falciparum) чаще всего используют: Лариам, Коартем и Маларон.
Рекомендации ВОЗ
Всемирная Организация Здравоохранения рекомендует лечение всех видов малярии с помощью артемизинин-комбинированной терапии (АКТ). Артемизинин (или его производные) + Примахин (для лечения рецидивов). Артемизинин не является производным хинина, его выделяют из полыни однолетней (Artemisia annua). ВОЗ.
Использование делагила к тропической форме малярии сейчас является практически бесполезным! Насколько мне известно (врачи сами мне это говорили), в наших больницах, кроме делагила, больше нет антималярийных препаратов, однако их можно приобрести отдельно, в аптеках города. Например, тот же Хинин выпускается в форме вместе с анальгином, однако содержание хинина очень низкое. Хлорохин (Делагил), Примахин являются менее вредными препаратами, чем Хинин, но из-за резистентности Plasmodium falciparum к Хлорохину, в обороте снова стал использоваться Хинин, который убивает все виды плазмодия. Примахин используется для профилактики рецидивов малярии, после основного выздоровления. В Африке популярен Коартем, хорошо справшяющийся с распространённой там тропической малярией.
ВАЖНО! На территории РФ, а также стран СНГ из антималярийных препаратов вы можете приобрести только Делагил, Фансидар, Анальгин с хинином. Другие препараты нужно либо заказывать из-за рубежа, либо привозить их с собой из стран, эндемичных к малярии.
При лечении малярии применяются, как правило, два вида препаратов. Сначала один, затем другой (например, сначала - делагил, потом - примахин). Дело в том, что в нашей крови могут жить разные формы плазмодия, половые и бесполые. Убивая одни формы, мы не убиваем другие, и человек всё ещё остаётся инфицированным, что может привести к рицедиву и заражению других людей в сезон активности комаров (летом).
В моём случае, при трёхдневной малярии делагил - вполне адекватное лекарство. После приёма делагила мне стали давать антибиотик доксициклин (в связке с супрастином), также возможен приём тетрациклина или клиндамицина. Кроме того, по одной таблетке хинина я употреблял, находясь в Папуа - Новой Гвинее и Бангкоке - в момент сильной лихорадки, на всякий случай. Я верил в результаты теста и полагал, что это не малярия, а грипп, осложненный из-за ослабленного иммунитета, но на всякий случай употребил хинин. Почему по одной таблетке? Потому что я давал это лекарство местным жителям, и им всегда было достаточно лишь одной таблетки, после чего они говорили, что чувствуют себя хорошо. Однако местные менее восприимчивы к недугу, нежели я, новичок! Они имеют частичный иммунный ответ, антитела к данному виду плазмодия.
Рецидивы малярии
Малярийные плазмодии могут впасть в "спячку" и находиться в теле человека многие годы, после чего могут опять проявиться симптомы заболевания. Для профилактики экзоэритроцитарных отдалённых рецидивов назначают Примахин либо Хиноцид. Загвоздка заключается в том, что на территории РФ примахин и хиноцид купить невозможно - они не являются сертифицированными препаратами. Их можно, например, привезти из-за границы. Поэтому получается, что для профилактики рецидивов наши врачи пробуют применение антибиотиков доксициклина, тетрациклина и пр. Однако данная терапия не всегда показывает положительный эффект, не убивая "спящие" формы плазмодиев.
Как вариант, можно использовать комплексную терапию Хинина/Хлорохина (ликвидация эритроцитарных, кровяных форм) + фансидар (ликвидация неэритроцитарных форм), она не гарантирует избавления от рецидивов, но может быть использована. Без применения соответствующих препаратов существует большой риск возникновения всё новых и новых клинических проявлений заболевания спустя месяцы и даже годы. P. vivax, P. ovale могут дремать в организме до 3 лет, P. malariae - десятки.
У меня рецидив случился после 2-х месяцев от окончания лечения. Поднялась температура, озноб, жар, потовыделение, боль в левом боку, покалывание на коже, словно слабые комаринные укусы. Я даже не сдавал кровь на анализ, а сразу начал принимать делагил - его легко купить в аптеках.
Профилактика малярии
Если вы отправились путешествовать в тропическую глушь, то обязательно запаситесь заранее антималярийными препаратами в крупных городах, которые вы будете проезжать. Выделите время, зайдите в аптеку и купите пару-тройку упаковок препарата. В Африке и в Индии очень распространена тропическая малярия, так что не берите туда делагил, а запаситесь хинином. Если не знаете, как употреблять тот или иной препарат, то пейте из расчета максимум 0.5 гр в день, больше не пейте, потому что он может вызывать побочные эффекты.
В 2015 году малярией переболело около 214 миллионов человек, из которых умерло 438 000. 90% из них находилось в Африке. ВОЗ
Для профилактики малярии вы можете использовать все те же препараты, что и для её лечения. Но стоит помнить, что если вы-таки заболели малярией, несмотря на приём препаратов, для её лечения вам необходимо использовать другой вид лекарств. Для профилактики применяют тот же хинин, примахин, лариам (мефлохин), маларон и др.
Однако, несмотря на небольшие дозы приёма препарата в профилактических мерах (2 раза в неделю, начиная за 2 недели до поездки, и 2 после), препараты всё равно оказывают вредное воздействие на организм из-за побочных эффектов. Целесообразнее всего лечить малярию уже по факту появления. Начать приём следует немедленно, при первых симптомах. Как только вы почувствовали повышение температуры - смело пейте ваши заветные таблетки согласно ранее подобранной дозировке.
Жизненный цикл малярийного плазмодия
Автор: Олег Приходько


